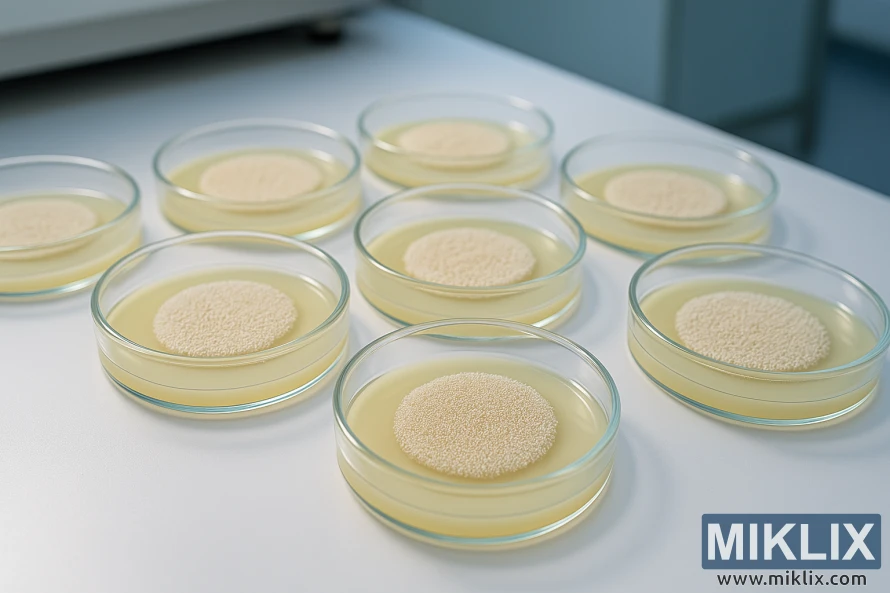
Several Petri dishes with visible brewer’s yeast colonies growing on pale yellow agar in a clean laboratory setting. Several Petri dishes with visible brewer’s yeast colonies growing on pale yellow agar in a clean laboratory setting.

Fermenting Beer with Bulldog B49 Bavarian Wheat Yeast
Published: November 9, 2025 at 12:14:10 AM UTC
This review highlights Bulldog B49 Bavarian Wheat Yeast as a prime choice for brewers aiming to craft authentic Bavarian wheat beers at home. It's specifically designed for Hefeweizen, Dunkelweizen, and Weizenbock. With its dry wheat profile and low flocculation, it promises a hazy appearance and a balanced finish, key elements sought by many homebrewers.

Bulldog offers B49 in 10 g sachets (item code 32149) and larger formats for commercial use, with kosher certification and EAC noted. The recommended dosage is one 10 g sachet per 20–25 L (5.3–6.6 US gallons). Many brewers achieve the best fermentation results near 21 °C (70 °F), which enhances the classic Hefeweizen yeast character.
Key Takeaways
- Bulldog B49 Bavarian Wheat Yeast suits traditional Bavarian wheat beers and Hefeweizen.
- Low flocculation yields a hazy pour with attenuation around 75–80%.
- Pitch one 10 g sachet per 20–25 L; ferment between 18–25 °C, target ≈21 °C.
- Available in 10 g sachets (item code 32149); store cool and use within recommended shelf life.
- Upcoming sections will cover handling, recipes, troubleshooting, and buying options.
Why choose Bulldog B49 Bavarian Wheat Yeast for homebrew wheat beers
Brewers opt for Bulldog B49 to achieve a genuine Bavarian wheat flavor in their Hefeweizen and southern German beers. This dry yeast strain is designed to replicate the classic banana and clove esters found in Hefeweizen. It also maintains the soft, pillowy mouthfeel that fans of the style adore.
The ideal yeast for Hefeweizen should produce a persistent haze and vibrant aromas. Bulldog B49 exhibits low flocculation, ensuring haze remains suspended and head retention is robust. This characteristic enhances the beer's appearance and aroma, making it authentic from the start.
Attenuation is crucial for achieving balance in beer. Bulldog B49 ferments at the higher end of attenuation, around 77 percent. This results in a drier finish, ideal for Dunkelweizen and Weizenbock. It counteracts rich malt sweetness without sacrificing the distinctive ester profile.
Practical advantages make Bulldog B49 appealing to homebrewers. It comes in a convenient dry-sachet format, which is easy to store when kept cool. Homebrewers value its shelf stability, Kosher certification, and packaging that aligns with common 10 g dosing for typical batch sizes.
- Flavor focus: strong banana/clove esters appropriate for classic wheat styles
- Appearance: sustained haze and soft mouthfeel from low flocculation
- Performance: high attenuation for a cleaner, balanced finish
- Practicality: dry sachets, shelf-stable storage, and common certifications
Choose Bulldog B49 for Hefeweizen, Dunkelweizen, Weizenbock, and any recipe seeking authentic Bavarian wheat characteristics. It offers the wheat beer yeast advantages brewers seek, ensuring recipes remain true to style.
Bulldog B49 Bavarian Wheat Yeast
The Bulldog B49 is a dry Bavarian wheat strain, perfect for clarity in wheat beers and balanced ester profiles. It comes in 10 g sachets for homebrewers and larger bricks for commercial use. Item codes like 32149 for the 10 g pack and 32549 for a 500 g brick are available. This variety caters to both small batches and large productions.
Attenuation for B49 typically ranges from 75% to 80%, with 78.0% being a common figure. This range helps brewers predict the final gravity and plan their mash profiles for the desired body and dryness. The yeast has a medium alcohol tolerance, suitable for most standard wheat beer strengths without stressing the yeast.
B49 flocculation is consistently low, which means the yeast stays suspended longer. This results in a fuller mouthfeel and haze typical of Bavarian wheat beers. Brewers aiming for clearer beer can allow extra time for settling or use gentle fining if needed. The low flocculation also aids yeast-driven flavor development during active fermentation.
The recommended fermentation range is between 18 °C and 25 °C (64–77 °F), with an ideal near 21 °C (70 °F). This balance between ester production and attenuation is crucial. Use one 10 g sachet per 20–25 L (5.3–6.6 US gallons) for typical pitches. Store the yeast cool to preserve viability; it is Kosher and EAC certified for quality assurance.
This strain is part of Bulldog's lineup of dry brewing yeasts, offering consistent performance for homebrewers and small breweries. The packaging and clear item coding make inventory and ordering straightforward for brewers who prefer established dry yeast formats.

Preparing wort for Bavarian wheat fermentation
Begin with traditional Bavarian grain mixes. For Hefeweizen, aim for 50–70% wheat malt and a balanced base malt. Dunkelweizen and Weizenbock benefit from 50–70% wheat, plus Munich or Vienna malts for color and depth.
Employ wheat mash techniques like step mashing or a single infusion at 64–67 °C to manage body. Target mash conversion to achieve the right mouthfeel after B49 fermentation. Adjust specialty malts to account for higher attenuation.
Set the target wheat wort gravity by style: moderate for Hefeweizen, elevated for Weizenbock. Remember, B49's 75–80% attenuation will leave less residual sugar than strains with lower attenuation. Raise mash temperature slightly for more dextrins and body.
Preserve haze-active proteins for a classic cloud. B49's low flocculation promotes haze, so avoid aggressive whirlpooling or over-clarification. This strips proteins crucial for the style's character.
Sanitation and temperature control are key at transfer. Cool the wort to around 21 °C before pitching. If using dry B49, ensure the wort is within this range for optimal rehydration and activity.
- For 20–25 L batches, plan oxygenation for B49 with either pure O2 or long, vigorous aeration to reach recommended dissolved oxygen.
- Avoid extreme pitching gravities unless you add extra oxygen and yeast nutrients to support healthy fermentation.
- Use gentle transfers to keep the desired haze and reduce oxygen pickup after initial aeration.
Measure and record wheat wort gravity at the end of the boil and after cooling. This helps predict final gravity given B49 attenuation and guides scheduling for conditioning and packaging.
Pitching and rehydration recommendations
For optimal results, follow Bulldog's B49 pitching rate: one 10 g sachet per 20–25 L (5.3–6.6 US gallons). This dosage ensures reliable cell counts for typical wheat beers, eliminating the need for complex starter steps.
The documentation supports the sprinkle on wort method for handling dry yeast. To avoid thermal stress, cool the wort to the target range before pitching.
Rehydrating Bulldog yeast is optional. However, rehydrating in sterile water at about 30–35 °C for 15–20 minutes can enhance initial viability. This is particularly beneficial for older packs or warmer climates.
If you decide to rehydrate, it's crucial to protect yeast cells from osmotic shock. After a 15–20 minute rest, add a small amount of wort to the slurry. Wait a few minutes, then add the yeast to the main batch.
Pitch when the wort temperature is between 18–25 °C, aiming for ~21 °C for the desired ester profile. Slow temperature shifts help yeast settle and perform predictably.
Ensure sanitation for any rehydration vessel and tools. For high-gravity brews like Weizenbock, consider yeast nutrient. It supports medium alcohol tolerance and steady attenuation.
- Dosage: 10 g per 20–25 L
- Preferred temps: pitch at 18–25 °C, aim for ~21 °C
- Methods: sprinkle on wort is acceptable; rehydration Bulldog yeast optional
- Rehydration steps: sterile water, 30–35 °C, 15–20 minutes, gradual wort acclimation
- Sanitation: clean rehydration vessel and tools
Fermentation temperature management
The B49 fermentation temperature is crucial for Bavarian wheat beers. It should be kept between 18–25 °C (64–77 °F). A temperature around 21 °C (70 °F) balances banana and clove flavors well, preventing overproduction of yeast esters.
Warmer temperatures, in the mid-20s, enhance esters and phenolics. This results in more pronounced banana and clove notes. On the other hand, cooler temperatures near 18 °C produce cleaner beers with milder fruit esters. It's important to avoid temperature spikes, as they can lead to off-flavors and lower attenuation.
To manage fermentation heat, consider using a dedicated fermentation chamber or a temperature-controlled refrigerator. For those on a budget, a swamp cooler with a digital thermostat or a temperature wrap is a cost-effective option. During the initial, most active phase, insulate or cool fermenters to control the primary fermentation exotherm.
- Set and monitor temps daily with a reliable thermometer or probe.
- Adjust target range based on desired yeast ester production and final flavor profile.
- Keep records of temp, gravity, and tasting notes for future batches.
After primary attenuation, a slight temperature rise for a diacetyl rest might be necessary. Ensure the beer is held long enough for flocculation and maturation. Note that Bulldog B49 exhibits low flocculation, which can result in a hazy beer despite proper conditioning.
Expected fermentation performance and timeline
Bulldog B49 exhibits a consistent fermentation timeline for wheat beers. Active fermentation starts within 12–48 hours at the right temperatures. You'll see krausen and airlock activity during this period.
For a standard Hefeweizen, primary fermentation wraps up in 4–7 days. Beers with higher gravity, like Weizenbock, will need more time. Always check fermentation progress with a hydrometer or refractometer, not just time.
Attenuation usually ranges from 75% to 80%, with 78% being common among commercial brewers. This results in a dry finish for wheat beers, keeping the banana and clove esters intact.
Yeast flocculation is low, so the beer stays hazy. If you want clarity, add extra conditioning time. Cold conditioning or fining agents can help clear the beer when needed.
B49 has a medium alcohol tolerance, fitting most Hefeweizens and many Weizenbocks. For high-gravity beers, adjust the pitch rate and yeast nutrition to ensure full attenuation and a stable final gravity.
Include practical checks in your fermentation schedule. Take gravity readings on days 3 and 7, confirm stable gravity over 48 hours, then package. Bottle or keg only when the terminal gravity is consistent and conditioning is complete.

Flavor and aroma outcomes when using B49
Bulldog B49 is celebrated for its classic B49 flavor profile, a hallmark of southern German wheat beers. It offers a distinct banana and clove ester profile, reminiscent of traditional Hefeweizen aromas. This balance creates a familiar, inviting scent that perfectly complements the wheat malt's character.
The fermentation temperature significantly influences the flavor. Fermenting at around 21 °C results in a balanced mix of banana and clove esters. However, increasing the temperature can enhance fruity esters, leading to a more ester-forward beer.
B49 is known for its phenolic properties, delivering a spicy clove character that many brewers desire. By controlling the pitch rate and temperature, brewers can fine-tune the phenolic intensity. This ensures the clove complements the banana esters without overpowering them.
This yeast exhibits low flocculation, contributing to the typical opaque appearance of Hefeweizen. It also keeps aroma compounds suspended, enhancing the beer's aroma. The mouthfeel is soft and pillowy, unless adjustments to the mash add more dextrins or specialty malts to increase body.
- Style fit: excellent for Hefeweizen, Dunkelweizen, and Weizenbock.
- Mouthfeel: higher attenuation yields a drier finish; mash design can increase body.
- Visual: haze is natural and aligns with Hefeweizen aroma expectations.
Small adjustments to the mash profile, fermentation schedule, or conditioning can significantly alter the B49 flavor profile. Brewers can aim for a fruitier or spicier taste by making these changes. This versatility makes B49 a flexible choice for those seeking authentic banana and clove esters with a true Hefeweizen aroma.
Yeast handling and storage best practices
Ensure Bulldog B49 remains cool from the moment of purchase to the time of use. Store unopened sachets or bricks in the refrigerator as soon as they arrive. This cold storage method helps maintain cell viability, leading to consistent fermentation results.
Adopting simple yeast storage best practices is crucial. Protect the packets from heat, light, and moisture. Also, note the lot codes and expiry dates on the packaging. This allows you to track the dry yeast shelf life and ensure proper stock rotation.
Packaging options depend on the scale of use. Bulldog B49 is available in 10 g sachets for single batches and 500 g bricks for repeated use. For larger purchases, follow vendor guidelines for refrigeration or freezing to extend the usable life.
When handling sachets, maintain cleanliness to prevent contamination. Open them on a sanitized surface and use clean tools. If rehydrating, use sterile water at the correct temperature and sanitized equipment to minimize microbial risks.
- Sanitize all contact surfaces and utensils before pitching.
- Avoid exposing yeast to warm ambient temperatures during transfer.
- Label opened sachets with the date and use within a short window for best results.
When ordering online, request expedited shipping or cold-pack options in warm weather. Shipments that arrive warm should be chilled immediately to protect viability and extend dry yeast shelf life.
For transport between locations, use insulated coolers or cold packs. Store Bulldog B49 in the coolest part of your fridge. Avoid storing it near strong-smelling foods to prevent aroma pickup.
Adopt sanitary pitching practices every time you brew. Proper handling combined with smart storage will keep viability high and reduce the chance of off-flavors during fermentation.

Common troubleshooting and off-flavor prevention
Temperature control is key. Aim for fermentation between 18–25 °C, with 21 °C for optimal ester balance. High temperatures can introduce solvent-like esters, spoiling the wheat beer's clean profile.
Oxygenation is crucial before pitching yeast. Ensure sufficient dissolved oxygen and use yeast nutrient for high-gravity brews like Weizenbock. Without enough oxygen or nutrition, yeast stress can lead to sulfurous or phenolic off-flavors.
Proper pitching rates are essential. For homebrews, one sachet per 20–25 L prevents slow or stuck fermentations. If fermentation stalls, check oxygen levels, temperature, and consider a fresh yeast pitch early.
- Check gravity and temperature first.
- Re-pitch with active yeast if needed.
- Aerate gently within the first 12–24 hours if fermentation is sluggish.
Accept some haze in B49. Its low flocculation means persistent turbidity is typical in Hefeweizen. For clearer beer, use finings, filtration, or extended cold conditioning, but some yeast will remain.
Be vigilant for contamination signs. Sourness, unusual pellicles, or off aromas beyond banana and clove indicate infection. Strict sanitation of fermenters and tubing can reduce risks.
- For phenol control, maintain stable temps and avoid excessive trub disturbance.
- To limit yeast stress, oxygenate wort and add yeast nutrient for rich worts.
- For stuck ferments, verify pitch rate and consider a fresh re-pitch with active yeast.
By following these steps, you can effectively troubleshoot and prevent off-flavors in B49. Paying close attention to oxygen, pitching, and temperature will help manage phenol control and reduce yeast stress-related faults.
Comparing Bulldog B49 with other Bulldog strains
Use this overview to compare Bulldog strains and where B49 fits in the Bulldog yeast lineup. B49 specializes in Bavarian wheat styles and highlights banana and clove esters at moderate temps. Its low flocculation and higher attenuation leave a softer mouthfeel and traditional wheat character.
When you look at B49 vs B1, expect different results. B1 Universal Ale attenuates around 70–75% with medium flocculation. B1 produces hoppier and fruitier notes that suit pale ales and amber ales. B49 keeps wheat phenolics front and center rather than hop-driven esters.
Compare Bulldog strains like B4 English Ale and B5 American West Ale to see yeast behavior for ales. B4 shows high flocculation and 65–70% attenuation, yielding fuller body and clearer beer. B5 runs 70–75% attenuation and gives a cleaner fermentation profile for hoppy, American-style ales. Those strains contrast with B49’s wheat-forward profile.
Bulldog’s Belgian and saison options change the playing field. B16 Belgian Saison ferments warm and reaches very high attenuation, often 85–90%. It creates spicy, tart notes suited to farmhouse beers. B49 remains more restrained in temperature and focused on classic wheat ester-phenolic balance.
Lag er strains in the Bulldog lineup, like B34 German Lager and B38 Amber Lager, function as bottom-fermenters at lower temps. They produce clean, crisp lager profiles at 9–14 °C. That lager character differs from B49’s top-fermenting, ester-forward signature.
- Attenuation and flocculation vary across the lineup; choose based on desired body and clarity.
- Fermentation temperature ranges determine ester and phenolic development.
- Select wheat vs ale yeast depending on style goals: B49 for wheat, others for diverse ale or lager profiles.
Recipe ideas and tested formulations
For a classic Hefeweizen, blend 50–70% wheat malt with 30–50% pale wheat or Pilsner malt. Aim for an original gravity of 1.048–1.056. Use one sachet per 20–25 L and ferment at 21 °C. This will enhance the banana and clove flavors. Expect a final attenuation of 75–78%, resulting in a light, refreshing beer.
Dunkelweizen recipes call for Munich and Caramunich malts to add color and toasty notes. Keep the OG similar to Hefeweizen or slightly higher for more body. B49's high attenuation dries the finish, so add specialty malts to maintain a full feel while preserving wheat beer esters.
Weizenbock recipes aim for an OG of 1.070 or higher. B49 manages medium alcohol levels well. Plan for staggered nutrient additions and consider a higher pitching rate or multiple sachets for larger batches. Ferment between 20 and 22 °C, monitoring for stress signs.
- Hops and additions: choose low-AAU noble hops for subtle bitterness. Keep hops minimal to let wheat yeast esters lead the aroma.
- Mash schedule tips: use a moderately high mash temperature or a step mash to add body if B49's attenuation makes the beer too thin.
- Dosing: follow Bulldog dosing guidance—one sachet per 20–25 L. Adjust for higher-gravity brews as needed.
Practical batch checklist:
- Record target OG and adjust specialty malts for color and mouthfeel.
- Rehydrate or pitch per manufacturer instructions and match pitch rate to gravity.
- Set fermentation temperature to control ester profile rather than adding spices.
- Allow extra conditioning time due to low flocculation before packaging.
When experimenting with wheat beer recipes using Bulldog B49, start with a traditional B49 Hefeweizen recipe. Then, move to a darker Dunkelweizen recipe and a robust Weizenbock formulation. Each base can be fine-tuned by adjusting the mash schedule, specialty malts, and careful pitching. This will highlight the yeast's unique character.
Packaging, conditioning, and carbonation tips
When packaging wheat beer, consider the beer's final gravity. Bulldog B49 can attenuate well, so confirm gravity is stable over several days before priming or transferring to kegs. For Weizenbock and higher gravity brews, check attenuation twice to avoid overcarbonation.
Allow secondary conditioning or extended maturation to calm volatile esters when conditioning B49 beer. Expect a persistent haze due to low flocculation. If clarity matters, cold crash, use finings, or filter after primary; these steps will reduce haze and may soften some yeast-driven aromas.
Choose a carbonation method that matches your serving goals. Traditional Hefeweizen benefits from lively bubbles and strong head retention. Target about 3.5–4.5 volumes CO2 depending on the style. Use kegging with regulated CO2 for precise control or calculate bottle-conditioning dosages for safe levels in 20–25 L batches.
- Before bottle-conditioning, verify stable final gravity to reduce bottle bombs.
- For kegging, carbonate cold and test volumes with a sample glass.
- If packaging wheat beer for distribution, pasteurize or stabilize to limit continued fermentation from residual sugars.
Storage after packaging is crucial. Cooler temperatures slow conditioning and preserve delicate clove and banana notes. Be mindful that residual yeast in suspension supports traditional haze and may slowly condition beer in bottles or casks.
For brewers seeking consistency, document priming sugar amounts, keg pressure, and conditioning time. Small adjustments to carbonating Hefeweizen and conditioning B49 beer across batches will help dial in your ideal effervescence and flavor balance.
Conclusion
Bulldog B49 Bavarian Wheat Yeast is a standout in homebrewing, known for its ability to produce classic banana and clove esters. This review emphasizes its low flocculation, resulting in a hazy appearance. It also highlights its high attenuation, around 75–80%, which leads to a drier finish. This makes it ideal for Hefeweizen, Dunkelweizen, and Weizenbock.
For effective use, follow Bulldog's dosing instructions, using one sachet per 20–25 L. Pitch the yeast near the middle of the recommended range, around 21 °C. Store the packets cool until you're ready to use them. If you're brewing high-gravity batches, remember its medium alcohol tolerance. You might need to use nutrients or increase the pitch rate to avoid off-flavors.
Be prepared for a persistent haze and plan your conditioning and packaging accordingly. If you prefer a cleaner, clearer beer or a different ester balance, consider other Bulldog strains. The final verdict is that Bulldog B49 is excellent for Hefeweizen enthusiasts. It offers authenticity, ease of use, and a true Bavarian character. This makes it easy to achieve traditional wheat-beer results at home.
Further Reading
If you enjoyed this post, you may also like these suggestions:
- Fermenting Beer with Lallemand LalBrew New England Yeast
- Fermenting Beer with White Labs WLP802 Czech Budejovice Lager Yeast
- Fermenting Beer with White Labs WLP095 Burlington Ale Yeast
